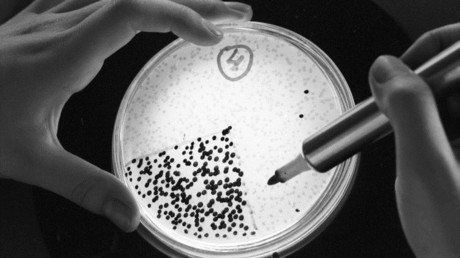
Bacteria del 'hombre de hielo' desconcierta a los científicos

Un equipo de genetistas europeos ha descubierto que la vestimenta de Ötzi, la momia de la Edad de Bronce encontrada en 1991 en los Alpes italianos, se confeccionó con las pieles de varios animales, según un estudio publicado en la revista 'Scientific Reports'. Hoy no habría sido muy bien tratado en las redes sociales por los defensores de la fauna.
Las prendas de Ötzi horrorizarían a los defensores de animales: el 'hombre de hielo' llevaba un sombreo de piel de oso, abrigo de cuero de cabra y oveja, pantalones también hechos con cuero de cabra. Y sus 'zapatos' eran rellenados con heno y para darles forma se empleaban ligamentos de vaca.
Estas fueron algunas de las prendas con las que Ötzi vestía en el momento de su muerte, ocurrida hace 5.300 años. Por si fuera poco, los investigadores también han hallado una funda para flechas hecha con piel de corzo. "Hemos analizado el ADN mitocondrial de nueve piezas de cuero y se identificaron cinco especies de animales diferentes", han explicado los autores del estudio.
Anteriores estudios habían vinculado a la momia con la actividad agropastoril, pero ahora los científicos creen que estas prendas y la funda para flechas proporcionan evidencia de que se dedicaba a la caza de animales salvajes.